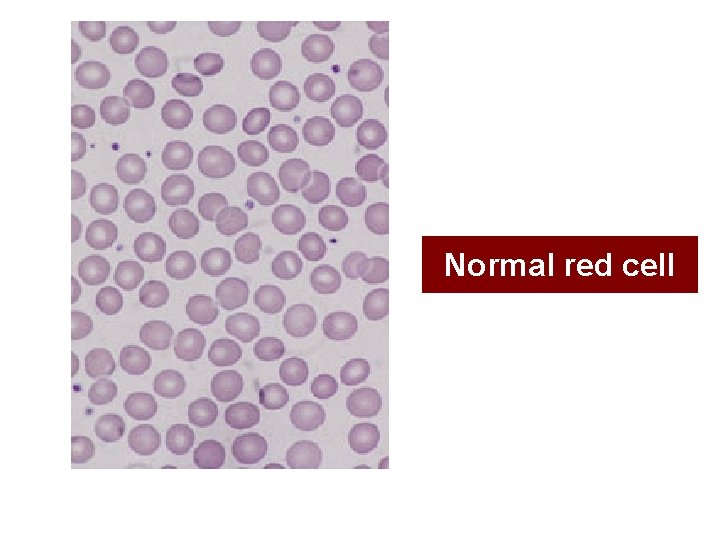
Normal red cell
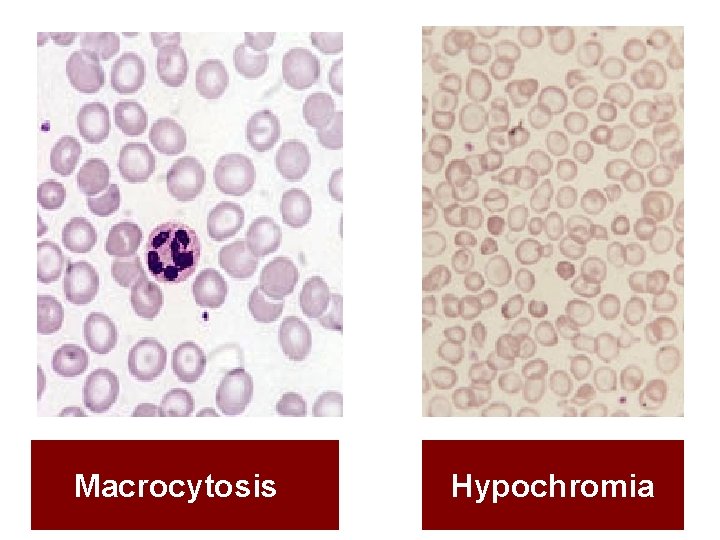
Macrocytosis Hypochromia
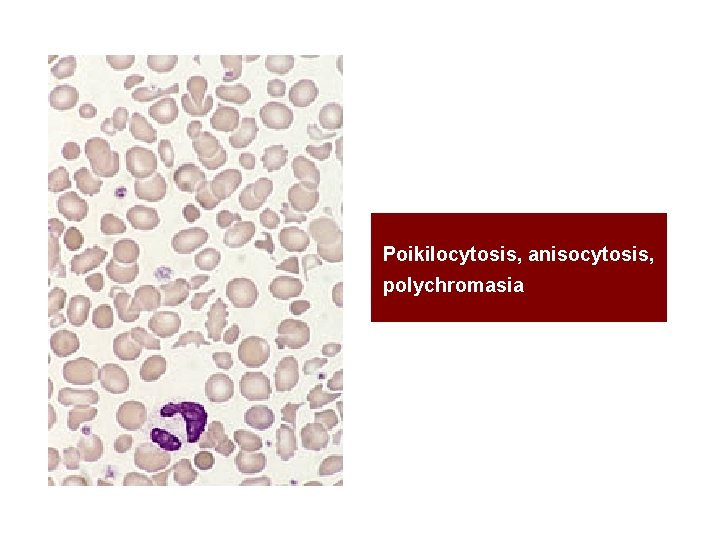
Poikilocytosis, anisocytosis, polychromasia

Approach to the adult with anemia Dr Yldz

- Slides: 46
Approach to the adult with anemia Dr. Yıldız Okuturlar İç Hastalıkları AD
Approach to the adult with anemia • • • Iron deficiency B 12 and folate deficiency Chronic disease/inflammation Hemolytic anemia Drug-induced Myelodysplastic syndrome Hemoglobinopathies Aplastic anemia Microangiopathic hemolytic anemia
DEFINITIONS • Anemia – A low hemoglobin concentration or a low hematocrit – Hemoglobin (g/d. L): the major oxygen-carrying molecule in whole blood – Hematocrit (%): calculated (HCT = [RBC x MCV]/10). Hemoglobin < 13. 5 g/d. L (adult males) < 11. 5 g/d. L (adult females)
• World Health Organization (WHO) criteria for anemia – men <13 – women<12 g/d. L,
Red blood cell indices • MCV • Mean corpuscular volume (MCV) is the average volume (size) of the patient's RBCs. • It can be measured or calculated – (MCV in femtoliters [f. L] = 10 x HCT [in percent] ÷ RBC [in millions/micro. L]). • Anemia can be classified based on whether the MCV is low, normal, or elevated.
Evaluation of anemia in the adult according to the mean corpuscular volume
Red blood cell indices • MCH • Mean corpuscular hemoglobin (MCH) is the average hemoglobin content in a RBC. • It is calculated – MCH in picograms [pg]/cell = hemoglobin [in g/d. L] x 10 ÷ RBC [in millions/micro. L]). • A low MCH indicates decreased hemoglobin content per cell, and is typically reflected in hypochromia on the peripheral blood smear. • This may be seen in iron deficiency and hemoglobinopathies like thalassemias
Red blood cell indices • MCHC • Mean corpuscular hemoglobin concentration (MCHC) is the average hemoglobin concentration per RBC. • It is calculated as – (MCHC in grams [g]/d. L = hemoglobin [in g/d. L] X 100 ÷ HCT [in percent]). • Very low MCHC values are typical of iron deficiency anemia, and very high MCHC values typically reflect spherocytosis or RBC agglutination. • Examination of the peripheral blood smear is helpful in distinguishing these findings.
Red blood cell indices • RDW • Red cell distribution width (RDW) is a measure of the variation in RBC size, which is reflected in the degree of anisocytosis on the peripheral blood smear. • A high RDW implies a large variation in RBC sizes, and a low RDW implies a more homogeneous population of RBCs. • RDW is calculated as the coefficient of variation (CV) of the red cell volume distribution – RDW = [standard deviation/MCV] x 100 • A high RDW can be seen in a number of anemias, including iron deficiency, myelodysplastic syndrome, and hemoglobinopathies, as well as in patients with anemia who have received transfusions. • Review of the peripheral blood smear often is helpful in identifying the cause of large variations in RBC size.
MALE Haemaoglobin (Hb) (g/d. L) FEMALE 13. 5 -17. 5 11. 5 -15. 5 Haematocrit (Htc) (%) 40 -52 36 -48 Red cell count (x 1012/L) 4. 5 -6. 5 3. 9 -5. 6 Mean cell haemoglobin (MCH) (pg) 27 -34 Mean cell volume (MCV) (fl) 80 -95 Mean cell haemoglobin concentration (MCHC) (g/d. L) 30 -35
Reticulocytes The normal range (ie, percent of RBC with positive staining) in adults is 0. 5 to 2. 0 percent
Signs and symptoms of anemia • Symptoms related to anemia can result from two factors: – decreased oxygen delivery to tissues – in patients with acute and marked bleeding, the added insult of hypovolemia.
Signs and symptoms of anemia Decreased oxygen delivery • The primary symptoms include – – Exertional dyspnea Dyspnea at rest Varying degrees of fatigue Signs and symptoms of the hyperdynamic state • bounding pulses • palpitations • a roaring pulsatile sound in the ears – More severe anemia may lead to • lethargy • confusion • potentially life-threatening complications – congestive failure – angina, arrhythmia – myocardial infarction
Signs and symptoms of anemia Hypovolemia • The earliest symptoms include – Easy fatigability – Lassitude – Muscle cramps • This can progress to – – Postural dizziness Lethargy Syncope In severe cases • persistent hypotension • shock • death
CLASSIFICATION OF ANEMIA: 1 -Depends on etiology (causes) 2 -Depends on red cell indices
CAUSES OF ANEMIA: – BLEEDING – DIMINISHED PRODUCTION – DESTRUCTION – DILUTION / SEQUESTRATION
CLASSIFICATION OF ANEMIA: Depends on etiology (causes) Failure in red blood cell production An abnormality in cell maturation An increase in cell destruction/loss
Depends on etiology (causes) Failure in red blood cell production MEANS Hypoproliferative anemias
Depends on etiology (causes) Failure in red blood cell production Hypoproliferative anemias Failure in the erythroid marrow production response - damage to marrow structure - damage to precursor stem cell pool - lack of stimulation by erythropoetin - iron deficiency Low reticulocyte index (< 2) Little or no changes in red cell morphology (normocytic)
CAUSES of HYPOPROLIFERATIVE ANEMIAS Marrow Damage: Chemotherapy/radiotherapy, Chemical toxins, heavy metals, Drugs, Infections, Leukemias/lymphomas PNH, Metastatic malignancy, Granulomatous disease, Radiation, Gaucher’s disease Myelofibrosis, GVHD, Aplastic anemia, Congenital disorders (Fanconi Aplastic anemia) Iron Deficiency: Lack of Stimulation of Bone Marrow: Renal disease, Chronic ilness (inflammatory disorders) Metabolic disease
Depends on etiology (causes) Abnormality in cell maturation MEANS Ineffective hematopoiesis
Depends on etiology (causes) Abnormality in cell maturation Deficiencies in vitamins (folic acid, vitamin B 12) Exposure to chemotherapeutic agents Low reticulocyte index (< 2) Microcytic or macrocytic red cell morphology
Depends on etiology (causes) Causes of maturation disorders Cytoplasmic defects: Thalassemia Iron deficiency Sideroblastic Nuclear maturation defects: Folate deficiency Vitamin B 12 deficiency
Depends on etiology (causes) Increase red blood cell production MEANS Hemolysis/increase blood loss
Depends on etiology (causes) Increase red blood cell production Blood loss or hemolysis stimulates a compansatory red blood cell production response. Increased reticulocyte index
Base on red cell indices Microcytic; MCV<80 f. L MCHC < 27 pg Normocytic; MCV: 80 -95 fl MCHC > 26 pg Macrocytic; MCV > 95
MICROCYTIC NORMOCYTIC MACROCYTIC MCV < 85 f. L MCV 80 -95 f. L MCV > 95 f. L Iron deficiency anemia Early iron deficiency Megaloblastic anemias Vitamin B 12 deficiency Folate deficiency Thallassemia Anemia of renal insufficiency Alchol or tobacco abuse Anemia of Chronic disease Temporal arteritis Rheumatoid Arthiritis Chronic Osteomiyelitis Anemia of Chronic disease Liver disease Hypothyroidism Sideroblastic anemia Hemolytic anemias Acute hemolytic anemia Hodgkin Disease Non thalassemic hb-pathies Intoxications (Pb, Cu) Aplastic anemia Drug induced Bone marrow supression Drug effects (Hydroxyurea) Bone Marrow infiltration Metatstatic cancer Hematologic malignancies Myelofibrosis Myelodysplastic syndrome
Hb < 12 g/d. L CBC Reticulocyte Index MCV: Reticulocyte index: Normocytic <2 Hypoproliferatif (low production) Macrocytic Microcytic <2 Maturation disorders (ineffective) Normocytic > 3 -5 Hemolysis (high production)
Normal red cell
Microcytic hypocromic anemia
Macrocytosis Hypochromia
Anisocytosis Anisochromasia
Poikilocytosis, anisocytosis, polychromasia
Reticulocytes
Reticulocyte count: Defination of Reticulocyte; young red blood cell containing residual ribosomal RNA that can be stained with supravital dye ( acridine orange new methylene blue)
Reticulocyte count: Prominant role in initially classifying any anemia The normal count is 0. 5 -2. 0 % Absolute count 25 -75 x 10 -9/L Absolute reticulocyte percentage; (%reticulocytes) x (patient htc/45) Absolute reticulocyte count; (%reticulocytes) x (red blood cell count)
Reticulocyte count: • Distinguished by reticulocyte count – Decreased in states of decreased production – Increased in destruction of red blood cells)
Reticulocytes
• DO NOT FORGET…! • First step of evaluation of anemia; • Check hemogram – MCV – WBC – Platelet • Reticulocyte index
IRON DEFICIENCY Laborauary Tests MCV MCHC Fe TIBC TRANSFERIN SATURATION FERRITIN
DIFFERENTIAL DIAGNOSIS Anemia of Chronic Disease Serum Iron Deficiency ACD Transferrin Ferritin
HEMOLYTIC ANEMIAS- Diagnosis